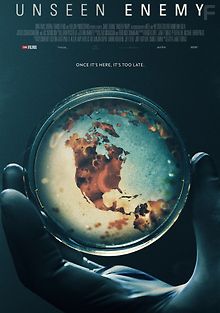
Невидимый враг

Обновлено: 25.02.2019
Unseen Enemy
Невидимый враг
Документальные
2017
1ч 38м
42
2
3
1
0
4
68
0
0
20
42
19
0
0
7
4
0
6
2
1
1
1
3
1
8
25
5
0
0
3
0
0
0
0
0
2
42
2
1
1
16
1
1
2
2
12
1
38
0
0
Поделиться:
закрыть
Скопировать ссылку
7.3
0
3.47
17
32
Описание
Документальный фильм, повествующий об эпидемиях 21 века и о борьбе с ними.
Страна
Бразилия
Китай
Сингапур
Таиланд
Швейцария
США
Германия
Великобритания
ДР Конго
Камбоджа
Либерия
Республика Конго
Сьерра-Леоне
Жанр
Переводы
Многоголосый, P - Синема УС
Похожие фильмы

+5
2021
Документальные Чернобыль: невидимый враг

+25
1958
Боевики Невидимый враг. Боевые пловцы

+13
1989
Приключения Невидимый враг

2025
Боевики Невидимый враг

1
2022
Драмы Невидимый враг

+1
2015
Исторический BBC. Невидимый Рим

9
2021
Документальные Принц Филипп: невидимый король

+100
2011
Детектив Ванга: Мир видимый и невидимый

+11
2013
Документальные Извините, мы не знали, что он невидимый

+10
2017
Документальные Кукушка - враг в моем гнезде
Наслаждайся просмотром без рекламы
Правила коментариев
Санкции
Комментарии, нарушающие эти правила, могут быть отредактированы или удалены модераторами. Систематические нарушения приводят к блокировке учетной записи. Администрация сайта оставляет за собой право применять санкции без предварительного уведомления.